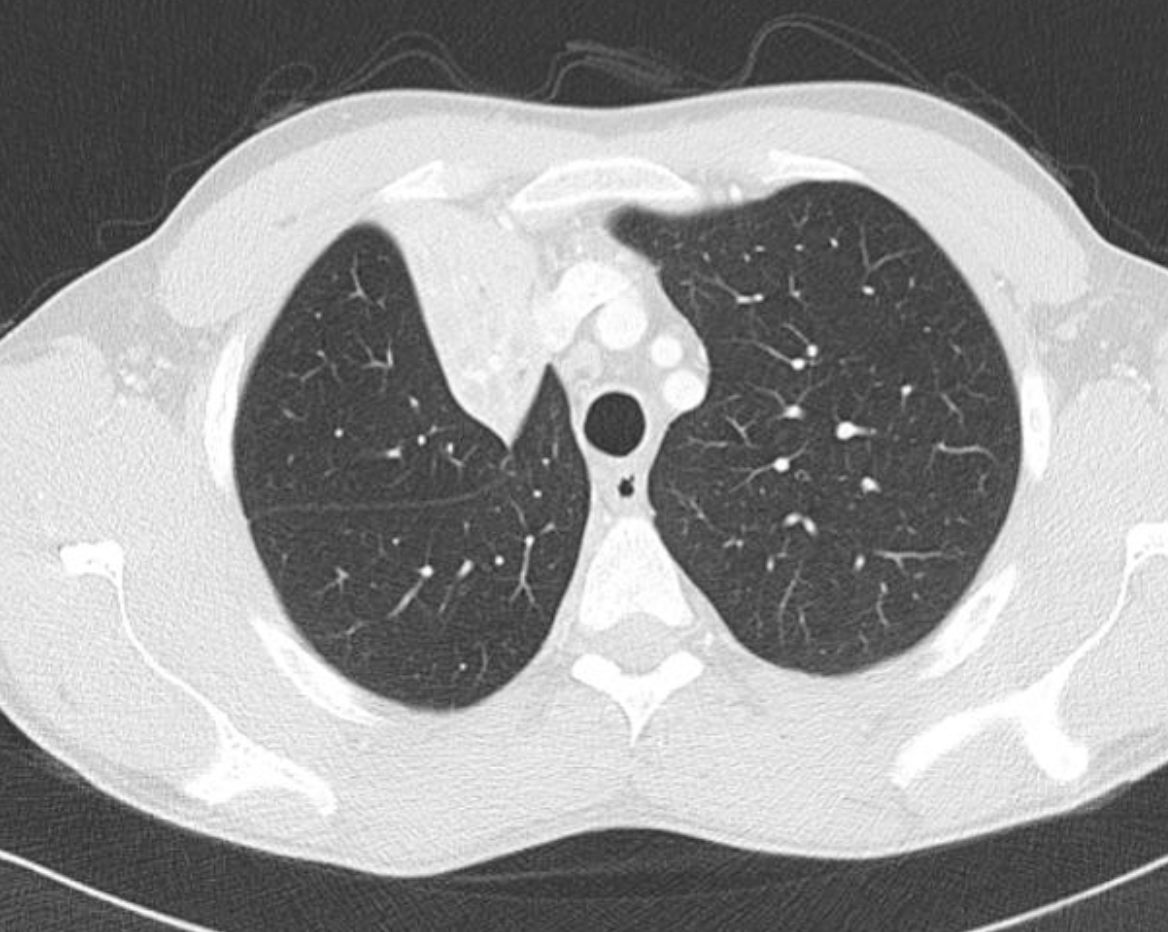

Causes of lung cavity
Wegener’s
Malignancy
Abscess
Infarct
Infection/TB
Rheumatoid nodule
Mnemonic:
Where Is Ina, My Research Assistance?
Causes of miliary shadowing
TB
Sarcoid
Metastasis
Causes of upper zone fibrosis
CHARTS
Ccoal worker pneumoconiosis
Histiocytosis-X
Ankylosing spondylitis
Radiation
TB
Sarcoidosis/ Silicosis
Causes of lower zone fibrosis
RASID
Rheumatoid arthritis
Asbestosis
Scleroderma/SLE
IPF
Drugs
Causes of mosaic attenuation
= patchwork of different attenuation on CT scan
1) Obstructive small airway disease –> air-trapping:
- smaller vessels in low attenuated area sec to vasoconstriction,
- mosaicism accentuated by expiration
2) Occlusive vascular disease: CTEPH (causes oligemia)
- smaller vessels in low attenuated area sec to vasoconstriction.
3) Other vascular problem: pulm oedema/ haemorrhage
4) infiltrative: e.g. HP, GGO, acute/ subacute infection
- vessels similar in size in low and high attenuated area
What are the RUL collapse features on CXR?
CXR features: (11)
- Increased density in the upper medial aspect of the R hemithorax
- Elevation of horizontal fissure
- Loss of the normal R medial cardiomediastinal contour
- Elevation of R hilum
- Intermediate bronchus appears more horizontal
- Hyperinflation of RML and LLL increased translucency on mid and lower parts of RL
- R justaphrenic peak
- S shape to elevated horizontal fissure if RUL collapse combines with R hilar mass (Golden S sign)
- Elevation of R hemidiaphragm
- Crowding of R sided ribs
- Shift of mediastinum and trachea to the R

What are the RUL collapse features on CT scan
CT features: (3)
Triangular opacification in axial image
Horizonal fissure rotates anteromedially
Oblique fissure bows anteriorly
What are the differentials for RUZ consolidation
RUL collapse
RUL consolidation – no volume loss
Mass – in medial aspect of RUL or R side of superior mediastinum
What are the features of RML collapse on CXR?
CXR features: (7)
R mid to lower air space consolidation – can be subtle in PA, so lateral CXR can help
Horizontal fissure no longer visible
Obscured R heart border
Elevated R. hemidiaphragm
Crowding of R sided ribs
Mediastinum shifted to the right
Displaced R hilum
Lateral CXR:
Triangular opacity projecting over cardiac shadow
Horizontal fissure not visible

What are the features of RML collapse on CT scan
CT features: (4)
Triangular opacification abutting R heartborder, thinner at the hilum in axial image
Horizonal fissure rotates anteromedially
Oblique feature bows anteriorly
RUL rotates anterolaterally and RLL rotates posterolaterally and meets lateral to the collapsed RML

What are the differentials to RLZ consolidation
RML consolidation - no volume loss
Pectus excavatum - downward sloping ribs and shift of heart away from the right side
What are the causes of lung collapse?
Luminal:
endobronchial mass
aspirated foreign body
mucous plugging
misplaced ETT
Mural: lung Ca
Extrinsic: compression by adjacent mass
What are the features of RLL collapse on CXR?
CXR features: (7)
Triangular opacity in RLZ medially with apex pointing toward R hilum
Obscured medial R hemidiaphragm
Inferior displacement of the right hilum
Obscured descending interlobular pulmonary artery
Distinct R heart border
Inferior displacement of horizontal fissure
Elevation of R hemidiaphragm
Crowding of R sided ribs
Shift of mediastinum to the right
Lateral CXR:
Triangular opacity in lower posterior chest
Obscured post R hemidiaphragm
Increased attenuation over the lower thoracic vertebrae
Oblique fissure displaced posteroinferiorly
Inferior displacement of R hilum

What are the features of RLL collapse on CT scan
CT features: (4)
Triangular opacification, thinner at hilum, against the posterior mediastinum/ spine and mediahemidiaphragm in axial images
Oblique fissure pulled posteriorly and rotate posteromedially
Compensatory hyperinflation of RUL & RML

What are the features of of LUL collapse on CXR
Luftsichel sign = due to hyperlinflation of the superior segment of LLL interposing itself between the mediastinum and collapsed LUL
L hilum drawn upwards
Almost horizontal course if LMB and vertical course of LLL bronchus
Elevation of L hemidiaphragm
Peaked/ tented hemidiapgram
Crowding of L ribs
Shift of mediastinum to L
Hazy opacification of the L hemithorax

What are the features of LUL collapse on CT scan
Triangular opacification in axial images, thinner at hilum
Anterior oblique fissre rotates anteromedially

What are the differentials of LUL opacities
L upper lobe consolidation – no volume loss
What are the features of LLL collapse on CXR
Retrocardiac sail sign: Triangular opacity in posteromedial L lung
Double cardiac contour
Inferior displacement of L hilum
Flat waist sign: flattening of L heart border
Obscured L hemidiaphragm
Obscured descending aorta
Preserved L heart border (which is contacted by the lingula of LUL)
Inferior displacement of oblique fissure
Elevation of L hemidiaphragm
Crowding of L ribs
Shift od mediastinum to the left
Lateral CXR:
Triangular opacification in lower posterior chest
Lower thoracic vertebrae appear denser

What are the features of LLL collapse on CT scan
Triangular opacification in axial images, thinner at hilum
Oblique fissure rotates posteromedially or posteriorly
Compensatory hyperinflation of LUL

What are the differentials of LLL opacities
L lower lobe consolidation – no volume loss
Pulm or posterior mediastinal mass
What are the causes of anterior mediastinal mass and imaging features
Tak Tentu Gila Lagi:
Thymus - thymoma/ thymus hyperplasia/ thymus carcinoma
Thyroid - goitre, thyroid carcinoma (send TFT)
Germ cell tumour (send AFP & BHCG)
Lymphoma (send LDH)
Imaging features:
What are the causes of middle mediastinal mass and imaging features
Lapar Betul Perut EV-NAC:
Lymph nodes - Ca/ infection/ lymphoma
Bronchogenic cyst
Pericardial cyst/ cardiac tumour
Esophageal mass – leiomyomas, cancer, hiatus hernia
Vascular (e.g. thoracic aortic aneurysm, pulm artery aneurysm, bronchial artery aneurysm)
Neurogenic tumour – vagal/ phrenic nerve
Abscess
Congenital – pericardial cyst, foregut duplication cyst
Imaging features:
What are the causes of posterior mediastinal mass and imaging features
Nak Bawa Masuk Pertandingan:
Neurogenic tumour – schwannoma, neurofibroma, paraganglioma
Non-neurogenic tumour – Ewing sarcoma, lymphoma, mets
Abscess
Vascular – descending thoracic aortic aneurysm
Bony lesion
Meningocele
Paraspinal abscess/ haematoma
Forgut duplication cysts
imaging features:
Radiation dose
- Normal yearly background radiation: 2.5 - 3.2mS (miliSieverts)
- CXR: 0.05mS
- Chest CT: 5 - 7mS
- HRCT: 1.5 - 2mS
- Low dose CT: 0.5mS
Resource: Fundamentals of body CT, page 8 (book author: Webb, Brant, Major)




